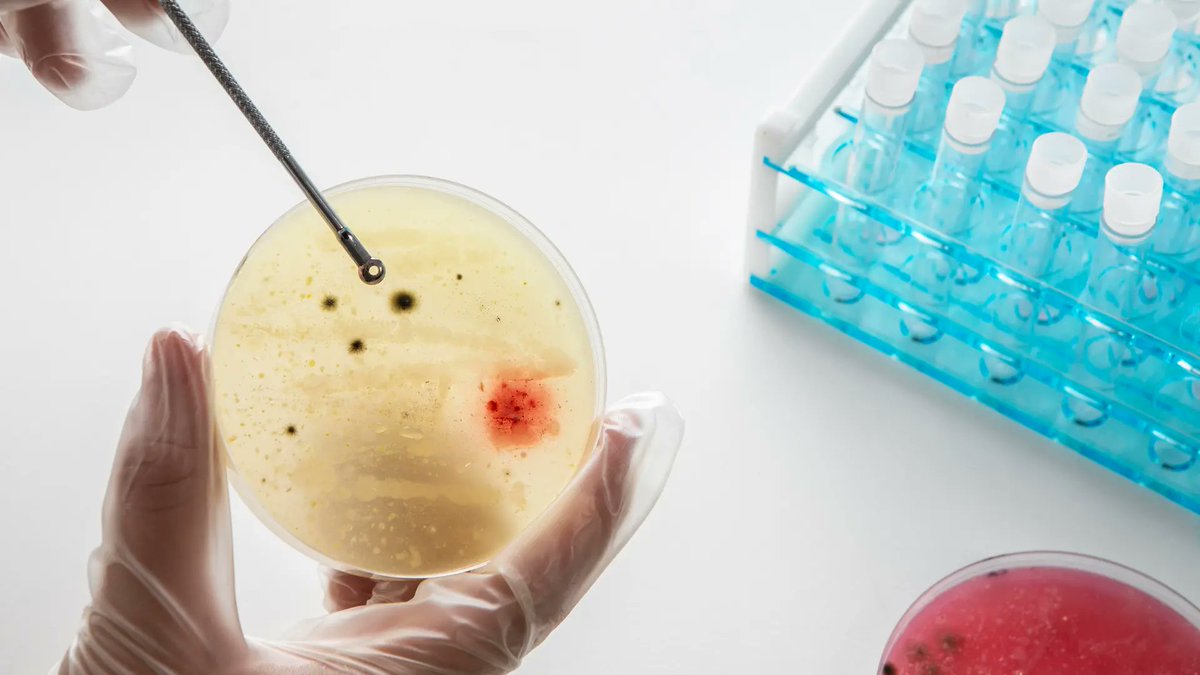

Microbial Evolution Lab, Dept. of ChE, IIT Bombay
@microbialevol
A group of biology enthusiasts working with @supreetsaini13 towards answering fundamental questions in evolutionary biology using microbes.
ID: 1588086115654770688
https://sites.google.com/view/esmlab/home 03-11-2022 08:30:31
184 Tweet
716 Takipçi
55 Takip Edilen

We are excited to share that Pavithra Venkataraman has been awarded the 2025 Smt Mangatayaru PhD thesis award. Congratulations Pavithra, and best wishes for every success ahead!

We are happy to share that Supreet Saini joins the Editorial Board of BMC Ecology and Evolution. Good luck, Supreet!

𝘾𝙖𝙣 𝙨𝙪𝙗𝙩𝙡𝙚 𝙛𝙤𝙤𝙙 𝙘𝙝𝙖𝙣𝙜𝙚𝙨 𝙡𝙚𝙖𝙙 𝙩𝙤 𝙫𝙖𝙨𝙩𝙡𝙮 𝙙𝙞𝙛𝙛𝙚𝙧𝙚𝙣𝙩 𝙚𝙫𝙤𝙡𝙪𝙩𝙞𝙤𝙣𝙖𝙧𝙮 𝙥𝙖𝙩𝙝𝙨? New research by IIT Bombay shows how microbes diverge when fed identical sugars packaged differently. Read: researchmatters.in/news/predictin… to dive deeper into

#IITBombay researchers use microbes to unlock nature’s hidden rules ✍🏼 Purnnima Sah trib.al/UZxcxmZ

Prof. R. Kumar Innovative Modelling Award 2025 Congrats to Dr. Pavithra Venkatraman & Prof. Supreet Saini (IIT Bombay) for their work on sympatric speciation in npj Systems Biology & Applications (2024). 📢 Lecture: Sept 13 | 10:30 AM 📍 ChemE, IISc Bangalore 🔗 QR code to join


New from our lab. Opposing copy-number variation dynamics shape adaptation to glucose vs galactose in diploid yeast. Read the preprint: biorxiv.org/content/10.110… prachitha n Saket Choudhary Supreet Saini



It was a pleasure to host Yashraj Chavhan in our group today! He shared with us his latest work on bacterial multicellularity. Thanks Yashraj for spending the day with us - look forward to hosting you again soon!
